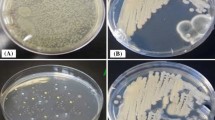

Abstract
Non-selective dumping and burning of agricultural waste have caused severe health hazards and environmental pollution. However, these waste materials can be utilized sustainably as soil fertilizer, renewable energy feedstock, and valorization for essential nutrients and phytochemicals. Being an agrarian country, India produces a significant amount of agricultural waste, further contributing to a severe environmental hazard. Therefore, there is a dire need to address this serious issue for the sustainable utilization of agricultural waste. In the present study, passion fruit bagasse (seed) was processed to extract valuable phytochemicals following several bioorganic chemistry techniques and then characterized for their identification and biological activities (in vitro antioxidant activity and antibacterial activity). 1H NMR, 13C NMR, HPLC, and mass spectrometry confirmed three vital phytochemicals of which two are stilbenoids and the other one is dihydroxy benzoic acid. These isolated and identified compounds were further subjected to in vitro antioxidant activity using DPPH assay, where the stilbenoid compounds showed superior results than the dihydroxy benzoic acid. However, these isolated compounds showed significantly higher antioxidant activity than other tested standard compounds like ascorbic acid, ferulic acid, and quercetin. This study indicated that futile waste passion fruit bagasse could be bio-processed for isolating value-added phytochemicals. Further, because of the crucial biological activity possessed by the isolated phytochemicals, their application in the food, health, pharmaceutical, and cosmetic sectors would be very promising.
Access provided by Autonomous University of Puebla. Download conference paper PDF
Similar content being viewed by others
Keywords
1 Introduction
Generally, the human antioxidant system balances antioxidant and reacting oxygen species like hydroxyl and superoxide inside the body. However, an unhealthy lifestyle and exposure to UV radiation accelerate reactive oxygen species (ROS) formation inside the body. Hence, the body’s defense system could not maintain balance. Free radical generation in cells causes oxidative stress that induces many life-threatening diseases such as cancer, diabetes, and senescence. These free radicals attack DNA, proteins, and lipids, promoting narcosis and cell death. To encounter these issues, external antioxidants in natural extracts or oxidative quencher medications are in high demand nowadays. These natural extracts are vitamins (ascorbic acid, α tocopherol), polyphenols (phenolic acid, stilbene, flavonoids, etc.), anthocyanins, carotenoids, etc. Polyphenols are well known for their anti-aging, antioxidant, antidiabetic, and anticancer properties. Previously, many plant extracts such as Anchusa italica [1], Clinacanthus nutans [2], and Avicennia marina [3] have also been analyzed for these activities.
Diabetes, more precisely type 2 diabetes, is of great health concern worldwide because of the concerning statistics [4]. When the pancreases cannot provide sufficient insulin to the body, carbohydrate metabolism gets delayed, resulting in an increase in sugar levels in the blood. Furthermore, reacting oxygen species also cause diabetes by accelerating oxidative stress in the body. Non-enzymatic glycosylation [5] is one of the possible mechanisms for oxidative stress-related diabetes. However, natural antioxidants isolated from different fruit, vegetables, and waste by-products (peel, seed, pomace, bark, leaves, root, etc.) can help reduce oxidative stress-related diabetes in the body.
Passiflora edulis var. flavicarpa (yellow passion fruit) is a not much-explored fruit in India. It is mostly consumed for its delicious juice, and the rest peel and seeds are discarded as waste or used for cattle feed [6]. The application of juice and rind has been considered by many research groups for food product application. Different varieties of passion fruit juice, rind, and their application in the field of food have been mentioned in Table 1. Passion fruit (PF) seed is one of the major waste by-products discarded directly by the beverage industries after juice extraction. They do not process the waste by-products for waste management which eventually increase environmental pollution. So far, for waste valorization, different sustainable approaches have been explored. Therefore, different methods for waste handling have been highly studied over the last decade. Reuse and recycling of agro-waste for the development of value-added products are often addressed first in the waste management hierarchy. The reuse of agro-waste to produce commercial products is growing day by day and is often called a bio-refinery process. Products developed from bio-refinery are classified as bio-fuels, bio-fertilizers, bio-chemicals, food additives, pigments, etc. [7]. For example, vegetable and fruit waste by-products are considered to isolate various pharmaceutically active ingredients to mitigate severe life-threatening diseases such as diabetes and oxidative stress.
In one of our recent studies [8], many polyphenols including gallic acid, caffeic acid, ferulic acid, p-coumaric acid, quercetin, myricetin, etc. have been identified from the peel and seed of yellow passion fruit. Those phytochemicals displayed profound antioxidant and antibacterial properties. However, many unidentified HPLC peaks encouraged us to further phytochemical mining of other prevalent novel compounds in the seed of PF. Therefore, in this study, systematic isolation approaches including fractionation, column chromatography, and preparative HPLC methods were followed to achieve maximum yield of Piceatannol (PT) and Protocatechuic acid (PCA) were targeted using various bioorganic tools followed by the assessment of their in vitro antioxidant and antidiabetic properties.
2 Materials and Methods
2.1 Sample and Chemicals
Yellow passion fruits (YPF) were collected from a local market in Manipur, India. Yellow passion fruit seeds (YPFS) were separated from the juice sacs and further dried and properly stored. All the chemicals used for extraction and fraction were of analytical grade and were procured from Nacalai Tesque Co. (Kyoto, Japan). Diaion HP20SS used for reverse phase column chromatography was purchased from Mitsubishi Chemical Co., Tokyo, Japan. Antioxidant standards were purchased from Sigma Aldrich. The α-amylase and α-glucosidase enzymes were purchased from Sigma Aldrich.
2.2 Extraction and Fractionation of Yellow Passion Fruit Seeds
Initially, the seed sample was extracted with n-hexane to remove the oleaginous substances. The hexane-defatted seed sample (37.5 g) was subjected to Soxhlet extraction using a methanol:water ratio of 80:20 for 48 h. Later, the hydro-alcoholic extract was concentrated using rotary evaporation. Finally, the dried extract was stored in a 4 °C refrigerator until future use. Fractionation of the extract was carried out using 6.5 g extract and with different solvents such as hexane, dichloromethane (DCM), ethyl acetate (EtOAc), and butanol (BuOH). Two volumes of each solvent were added to the separating flask for the complete extraction of various phytochemicals in respective solvents. Afterwards, the fractions were dried using a vacuum evaporator and stored at 4 °C. The EtOAc fraction was further treated with an equal volume of 1 M NaOH followed by an equal amount of 1 M HCl to achieve maximum phenolic acid in the said fraction. The polyphenol-rich HCl-treated EtOAc fraction was further evaporated, and the dried fraction was stored in a 4 °C refrigerator for later use.
2.3 Separation and Isolation of Purified Compounds
Major peaks from the EtOAc and BuOH fractions were identified using a gradient HPLC (Jasco 4000 series HPLC unit, PDA detector, and 5C18-MS-II Cosmosil Packed column at 35 °C). A volume of 5 µL of a sample (10 mg/ml stock) was injected with a solvent system of 5–40% acetonitrile and 0.5% formic acid for 0–30 min. Major peaks were identified at 254 and 330 nm. Further, the major peaks containing fractions were subjected to reverse phase column chromatography (RPCC) using HP20SS ion exchange to separate PT and PCA. The column was eluted sequentially from 20% up to 100% with methanol and different fractions were collected. All the fractions collected from the RPCC were analyzed through analytical HPLC, and the solvent system was optimized for further isolation through preparative HPLC. Further, the purified compounds (major peaks selected from the analytical HPLC) were isolated using a preparative HPLC (Jasco 875UV preparative HPLC coupled with UV detector) and Prep ODS Inertsil column (10 mm ID, 250 mm, GL Sciences Inc., Tokyo, Japan) using a column temperature of 35 °C with the optimized condition of 30% methanol with 0.5% formic acid at 254 nm. Required fractions of the samples (PT and PCA) were collected batch-wise. Finally, all eluent systems were mixed together and evaporated to obtain the purified samples. Finally, the purified compounds were stored in ambered color vials and kept at −20 °C in a refrigerator.
2.4 Characterization of Purified Compounds
The purified compounds such as PT and PCA were dissolved separately in CD3OD and analyzed through 1H and 13C-NMR (JEOL ECA 500 spectrometer, JEOL, Tokyo, Japan). The molecular mass of the purified compounds was obtained from a JMS-T100TD mass spectrometer (JEOL). The purified compounds were dissolved in a methanolic solution before carrying out mass spectrometry. The data were collected in ESI (electro-spin ionization) negative mode.
2.5 In Vitro Biological Activities of Piceatannol and Protocatechuic Acid
In vitro antioxidant activity of the purified PT and PCA was performed using DPPH and ABTS methods mentioned by Purohit et al. [8]. In brief, 3 mL of 2–10 µg/mL sample (dissolved in methanol) was mixed with 1 mL of DPPH (0.1 mM DPPH in methanol) following an incubation period of 30 min, and the absorbance was recorded at 517 nm. For, ABTS analysis, a sample of the same concentration was dissolved in 1 mL methanol and mixed with 3 mL of ABTS (diluted with water) following 20 min incubation, and the absorbance was recorded at 765 nm. The free radical inhibitory concentration of PT and PCA was further compared with six alternate standards such as gallic acid, caffeic acid, ferulic acid, ascorbic acid, p-coumaric acid, and quercetin.
The in vitro antidiabetic activity of purified PT and PCA was estimated by α-amylase and α-glucosidase activities These were determined by following the methodologies outlined in the relevant prior art article [17]. In brief, for α-amylase activity, 1–5 µg/mL of sample (50 µL) was treated with 50 µL of α-amylase (0.5 mg/mL in 0.1 M PBS, pH 6.8) for 15 min at 37 °C. Afterward, 1% starch solution (50 µL) was added to the mixture and left for another 20 min at 37 °C. Then, 100 µl of DNS solution was added followed by boiling for 15 min. Then, the samples were diluted with water (1 ml) and the absorbance was recorded at 540 nm. Acarbose was used as the standard. The inhibition percentage was estimated using the following Eq. 1:
where Abs cont. refers to the absorbance of the control group, BG represents absorbance of background, and Abssamp is the absorbance of the sample/standard compound.
The α-glucosidase activity of purified PT and PCA was also determined using a prior article [17]. In short, 1–5 µg/mL of the sample or 100–500 ng/mL of the standard were mixed separately with α-glucosidase enzyme (50 µL) and incubated for 15 min at 37 °C. After that, 1 mM of 4-Nitrophenyl-β-D-glucopyranoside (50 µL) was added to the solution following an incubation period of 20 min at 37 °C. Then, 100 µL of Na2CO3 was added to the mixture, and the absorbance was recorded at 405 nm. The inhibition percentage of α-glucosidase by PT and PCA was calculated using Eq. 1.
2.6 Statistical Analysis
Results reported for antioxidant and antidiabetic activities are presented as mean ± SD of two independent experiments in duplicates.
3 Results and Discussion
3.1 Extraction and Purification of Piceatannol and Protocatechuic Acid
The fruit sample, seed, and purified compounds with their structures are presented in Fig. 1. The purified compounds were derived from hydro-alcoholic extraction of the defatted seed sample followed by fractionation, column chromatography, and preparative HPLC.
From the hydro-alcoholic extraction of YPFS, 7.2 g (19.2%) extract was recovered. Further, 6.5 g extract was subjected to fractionation using various solvents mentioned in the materials and method section. After the fractionation process, the EtOAc and BuoH fractions yielded maximum extract quantities, i.e. 1.54 and 2.68 g, respectively. To identify the tentative PT and PCA, both EtOAc and BuoH fractions were subjected to gradient HPLC. Their respective chromatograms are presented in Fig. 2a, b. Further, the presumed PT was isolated using a preparative HPLC (Fig. 3a and the chromatograms for purified PT are presented in Fig. 3b. The intensity of presumed PCA was found to be very low in HPLC analysis (Fig. 3c). Hence, the compound was identified using a polyphenol standard protocatechuic acid (Fig. 3d), and the chromatogram of the purified PCA is presented in Fig. 3e.
3.2 Identification of Piceatannol and Protocatechuic Acid
The NMR and mass spectra of PT are presented in Fig. 4. The negative mode ESI–MS revealed the pseudo molecular ion peak at m/z 243.08 at [M–H]−. The chemical shift (δ), coupling constant (J), and peak signals (brt, brd, Dd, s, and d) of 1H NMR (500 MHz, CD3OD) are presented. These are δ: 6.15 (1H, brt, J: 2.2 Hz), 6.43 (2H, brd, J: 2.3 Hz), 6.72 (1H, brd, J: 2.5 Hz), 6.74 (1H, s), 6.75 (1H, s), 6.82 (1H, Dd, J: 1.9 Hz), 6.83 (1H, Dd, J: 2.2 Hz), 6.87 (1H, s), 6.90 (1H, s), and 6.97 (2H, d, J: 2.2 Hz). The chemical shift in 13C NMR (CD3OD) is as follows: δ: 40.3, 49.5, 102.5, 105.7, 113.7, 116.3, 120.1, 126.9, 129.6, 130.9, 141.2, 146.4 2, and 159.5. The result from this experiment was in accord with the literature data [18] which suggested that the purified compound is a stilbene compound termed piceatannol (C14H12O4).
From the 1H NMR, compound 2 was identified as Protocatechuic acid, as presented in Fig. 5. The negative mode ESI–MS of this compound showed the pseudo ion peak at m/z 153.02 at [M-H]−. The chemical shift (δ), coupling constant (J), and peak signals (brt, brd, Dd, s, and d) of 1H-NMR (600 MHz, CD3OD) are δ: 6.93 (1H, d, J: 8.0 Hz), 7.39 (1H, dd, J: 8 Hz, J: 1.5 Hz), and 7.42 (1H, d, J: 1.5 Hz). The amount of this compound was significantly less; hence the compound was identified using HPLC analysis by comparing the retention time with the standard compound. From the proton NMR and mass spectroscopy, the compound was assumed to be a dihydroxy benzoic acid and further, it was confirmed as the Protocatechuic acid (C7H6O4) from the HPLC analysis. The 1H NMR data are in agreement with the available data in a relevant prior article [19].
3.3 Biological Activity of Piceatannol and Protocatechuic Acid
The in vitro antioxidant activity of PT and PCA was measured by DPPH and ABTS methods, and their results are presented as IC50 value in Table 2. Further, inhibitory activity was compared with various standard compounds. Both PT and PCA exhibited profound antioxidant activity against the tested commercial antioxidant antioxidants. PT showed superior antioxidant activity against ferulic acid (9.80 ± 0.01), caffeic acid (5.77 ± 0.04), ascorbic acid (3.95), and quercetin (7.85 ± 0.01) in the DPPH assay. A similar trend was also noticed in the ABTS assay. Moreover, PCA showed significantly high antioxidant activity compared to all standard antioxidants as well as PT. Both PT and PCA underperformed the in vitro antioxidant activity in comparison to gallic acid (0.89 ± 0.01, DPPH assay). Both DPPH and ABTS analyses are based on the principle of electron transfer or hydrogen ion transfer [6]. The antioxidant molecules donate electrons or hydrogen ions to the free radicals and thereby quench and reduce them. Various reports suggest hydroxyl and methoxy groups have a major tendency for donating electrons [20], and therefore the profound antioxidant activity of PT [21] and PCA [22] can be argued. The present study indicates that passion fruit-derived PT and PCA are high in antioxidant activity than many commercial antioxidant product systems. Therefore, they can be considered for commercial application. This step could add to the valorization of the waste passion fruit seed.
The parametric data are presented in terms of the IC50 value after taking the mean of two individual experiments (in duplicate). All values (µg/ml) of antidiabetic and antioxidant experiments are presented as mean ± SD. NA refers to not applicable in the representation. Similarly, the abbreviations are PT—Piceatannol; PCA—Protocatechuic acid; GA—Gallic acid; FA—Farulic acid; CA—Caffeic acid; p-CA—p-Coumaric acid; AA—Ascorbic acid; and Q—Quercetin.
The PT and PCA isolated and identified from YPFS were verified for their in-vitro antidiabetic activity and in terms of two different polysaccharide digestive enzymes (α-amylase and α-glucosidase). The results are presented as IC50 values in Table 2. The PCA exhibited better antidiabetic activity (2.12 ± 0.02 µg/ml in α-amylase and 1.89 ± 0.02 in α-glycosidase activity) compared with PT. The antidiabetic activity of PCA in the present study is in accordance with the reported data [23, 24]. PCA is a well-known phenolic acid found in many plant species [23, 24] with profound antioxidant, antidiabetic, and anticancer activities. Moreover, delaying glucose absorption in the body to manage the postprandial glycemic level is one of the approaches being followed for type 2 diabetes [25]. The α-amylase and α-glucosidase digestive enzymes are major digestive enzymes that take part in carbohydrate digestion and thereby help in instantly increasing blood glucose levels. Nowadays, natural extract-driven inhibition of these enzymes for delaying carbohydrate digestion is mostly considered as an indirect antidiabetic approach. Stilbenes (resveratrol and its analogues) have been proven to have antidiabetic activity in the literature [26] due to the presence of maximum hydroxyl groups that assist in increasing the bioavailability of the compound [27]. PT is a stilbene molecule majorly found in different Prunus species and passion fruit seeds [21]. PT has also proven to be an oxidative stress quencher for many cancer diseases. Such an outcome exhibits more scope for the related evaluation of these compounds in terms of preclinical and clinical studies.
4 Conclusions
In summary, this study reported the isolation of PT and PCA from YPFS by employing various bioorganic chemistry steps, and furthering their antioxidant and antidiabetic activity. Both compounds were found to be effective antioxidant and antidiabetic molecules. PT and PCA were also found to show superior antioxidant activity against different standard polyphenols including caffeic acid, ascorbic, quercetin, etc. This study also reported that PT and PCA inhibited both α-amylase and α-glucosidase digestive enzymes. However, more evidence in terms of preclinical and clinical studies is required. Further, the study also depicted the valorization of waste passion fruit seeds for the isolation of bioactive phytochemicals such as PT and PCA. Such a research directive can open a prospectus for therapeutic product development from waste.
References
Khomsi, M.E., Imtara, H., Kara, M., Hmamou, A., Assouguem, A., Bourkhiss, B., Tarayrah, M., AlZain, M.N., Alzamel, N.M., Noman, O.: Antimicrobial and antioxidant properties of total polyphenols of Anchusa italica Retz. Molecules 27, 416 (2022)
Ban, W.K., Fong, I.L., Khong, H.Y., Phung, J.H.Y..: Wound healing, antimicrobial and antioxidant properties of Clinacanthus nutans (Burm. f.) Lindau and Strobilanthes crispus (L.) Blume extracts. Molecules 27, 1722 (2022)
Arbidar, E., Sahari, M.A., Mirzaei, H., Kashaninejad, M., Molaee, M..: Evaluation of the effect of gamma and microwave irradiation and high temperature on the antioxidant properties of the Avicennia marina leaf extract. Rad. Phys. Chem. 193, 109970 (2022)
Ding, Z., Zhao, Y., Liu, J., Ge, W., Xu, X., Wang, S., Zhang, J.: Dietary Succinoglycan Riclin improves Glycemia control in mice with type 2 diabetes. J. Agric. Food Chem. 70, 1819–1829 (2022)
Sabu, M., Kuttan, R.: Anti-diabetic activity of medicinal plants and its relationship with their antioxidant property. J. Ethnopharmacol. 81, 155–160 (2002)
Purohit, S., Kalita, D., Barik, C.R., Sahoo, L., Goud, V.V.: Evaluation of thermophysical, biochemical and antibacterial properties of unconventional vegetable oil from Northeast India. Mater. Sci. Energy Technol. 4, 81–91 (2021)
Schieber, A., Stintzing, F.C., Carle, R.: By-products of plant food processing as a source of functional compounds—recent developments. Trends Food Sci. Technol. 12, 401–413 (2001)
Purohit, S., Barik, C.R., Kalita, D., Sahoo, L., Goud, V.V.: Exploration of nutritional, antioxidant and antibacterial properties of unutilized rind and seed of passion fruit from Northeast India. J. Food Meas. Charact. 15, 3153–3167 (2021)
Soumya, R.S., Raj, K.B., Abraham, A.: Passiflora edulis (var. Flavicarpa) juice supplementation mitigates isoproterenol‐induced myocardial infarction in rats. Plant Foods Hum. Nutr. 76, 189–195 (2021)
Sathyan, A., Vincent, L., Krishna, B.A., Pradeepan, V., Dileep, A.C.: A study on the antioxidant and anti-microbial properties of juices of four varieties of passion fruit (Passiflora Edulis, Passiflora Foetida, Passiflora Edulis F. Flavicarpa and Passiflora Quadrangularis) (2019)
Jordán, M.J., Goodner, K.L., Shaw, P.E.: Characterization of the aromatic profile in aqueous essence and fruit juice of yellow passion fruit (Passiflora edulis Sims F. Flavicarpa degner) by GC−MS and GC/O. J. Agric. Food Chem. 50, 1523–1528 (2002)
dos Santos, E.A., Ribeiro, A.E.C., Barcellos, T.T., Monteiro, M.L.G., Mársico, E.T., Caliari, M., Júnior, M.S.S.: Exploitation of byproducts from the passion fruit juice and tilapia filleting industries to obtain a functional meat product. Food Biosci. 41, 101084 (2021)
Mendes, R.M.L., de Andrade, R.H.C., Marques, M.de.F.F., de Andrade, E.R.: Potential use of the passion fruit from Caatinga in Kefir. Food Biosci. 39, 100809 (2021)
De Toledo, N.M.V., De Camargo, A.C., Ramos, P.B.M., Button, D.C., Granato, D., Canniatti-Brazaca, S.G.: Potentials and pitfalls on the use of passion fruit by-products in drinkable yogurt: physicochemical, technological, microbiological, and sensory aspects. Beverages 4, 47 (2018)
Oliveira, P.N., dos Santos Gomes, P.C., Alcarde, A.R., Bortoletto, A.M., Neta, M.T.S.L., Narain, N., de Souza Abud, A.K., Júnior, A.M.O.: Characterization and volatile profile of passion fruit spirit. Int. J. Gastron. Food Sci. 21, 100223 (2020)
Santos, K.L, Alves, C.A.N., de Sousa, F.M., Gusmao, T.A.S., Alves Filho, E.G., de Vasconcelos, L.B.: Chemometrics applied to physical, physicochemical and sensorial attributes of chicken hamburgers blended with green banana and passion fruit epicarp biomasses. Int. J. Gastron. Food Sci. 24, 100337 (2021)
Swaraz, A.M., Sultana, F., Bari, Md.W., Ahmed, K.S., Hasan, M., Islam, Md.M., Islam, M.A., Satter, M.A., Hossain, Md.H., Islam, Md.S.: Phytochemical profiling of Blumea laciniata (Roxb.) DC. and its phytopharmaceutical potential against diabetic, obesity, and Alzheimer’s. Biomed. Pharmacother. 141, 111859 (2021)
Sano, S., Sugiyama, K., Ito, T., Katano, Y., Ishihata, A.: Identification of the strong vasorelaxing substance scirpusin B, a dimer of piceatannol, from passion fruit (Passiflora edulis) seeds. J. Agric. Food Chem. 59, 6209–6213 (2011)
López-Martínez, L.M., Santacruz-Ortega, H., Navarro, R.-E., Sotelo-Mundo, R.R., González-Aguilar, G.A.: A 1H NMR investigation of the interaction between phenolic acids found in Mango (Manguifera indica cv Ataulfo) and Papaya (Carica papaya cv Maradol) and 1, 1-diphenyl-2-picrylhydrazyl (DPPH) free radicals. PloS One 10, e0140242 (2015)
Parcheta, M., Świsłocka, R., Orzechowska, S., Akimowicz, M., Choińska, R., Lewandowski, W.: Recent developments in effective antioxidants: the structure and antioxidant properties. Materials 14, 1984 (2021)
Banik, K., Ranaware, A.M., Harsha, C., Nitesh, T., Girisa, S., Deshpande, V.: Piceatannol: a natural stilbene for the prevention and treatment of cancer. Pharmacol. Res. 153, 104635 (2020)
Adefegha, S.A., Oboh, G., Ejakpovi, I.I., Oyeleye, S.I.: Antioxidant and antidiabetic effects of gallic and protocatechuic acids: a structure–function perspective. Comp. Clin. Pathol. 24, 1579–1585 (2015)
Andrade, J.K.S., Barros, R.G.C., Pereira, U.C., Gualberto, N.C., de Oliveira, C.S., Shanmugam, S., Narain, N.: α-Amylase inhibition, cytotoxicity and influence of the in vitro gastrointestinal digestion on the bioaccessibility of phenolic compounds in the peel and seed of Theobroma grandiflorum. Food Chem. 373, 131494 (2022)
Gedük, A.Ş., Atsız, S.: LC-MS/MS phenolic composition of peach (Prunus persica L. Batsch) extracts and an evaluation of their antidiabetic, antioxidant, and antibacterial activities. S. Afr. J. of Bot. 147, 636–645 (2022)
Mechchate, H., Es-Safi, I., Louba, A., Alqahtani, A.S., Nasr, F.A., Noman, O.M., Farooq, M., Alharbi, M.S., Alqahtani, A., Bari, A.: In vitro alpha-amylase and alpha-glucosidase inhibitory activity and in vivo antidiabetic activity of Withania frutescens L. Foliar extract. Molecules 26, 293 (2021)
Dirir, A.M., Daou, M., Yousef, A.F., Yousef, L.F.: A review of alpha-glucosidase inhibitors from plants as potential candidates for the treatment of type-2 diabetes. Phytochem. Rev. 1–31 (2021)
Tran, H.H.T., Nguyen, M.C., Le, H.T., Nguyen, T.L., Pham, T.B., Chau, V.M., Nguyen, H.N., Nguyen, T.D.: Inhibitors of α-glucosidase and α-amylase from Cyperus rotundus. Pharm. Biol. 52, 74–77 (2014)
Acknowledgements
The authors extend their gratitude to the School of Energy Science and Engineering, Indian Institute of Technology, Guwahati, and United Graduate School of Agricultural Science, GIFU University, for providing research laboratory facilities to conduct the work mentioned in this manuscript. The work presented in this article was financially supported by a joint research grant [vide Grant No. BT/311/NE/TBP/2012] from Department of Biotechnology (DBT), Ministry of Science and Technology, New Delhi, India. A part of the research work was also carried out with the financial support of the Japan Student Services Organization (JASSO).
Author information
Authors and Affiliations
Corresponding author
Editor information
Editors and Affiliations
Ethics declarations
Conflict of Interest
All the authors declare no conflict of interest among each other.
Rights and permissions
Copyright information
© 2023 The Author(s), under exclusive license to Springer Nature Singapore Pte Ltd.
About this paper
Cite this paper
Purohit, S., Yanase, E., Sahoo, L., Goud, V.V. (2023). Assessment of Biological Activities of Various Phytochemicals Isolated from Passion Fruit Bagasse. In: Uppaluri, R.V., Das, C., Goud, V., Anandalakshmi, R. (eds) Agro and Food Processing Technologies. NERC 2022. Springer, Singapore. https://doi.org/10.1007/978-981-19-9704-4_1
Download citation
DOI: https://doi.org/10.1007/978-981-19-9704-4_1
Published:
Publisher Name: Springer, Singapore
Print ISBN: 978-981-19-9703-7
Online ISBN: 978-981-19-9704-4
eBook Packages: Biomedical and Life SciencesBiomedical and Life Sciences (R0)